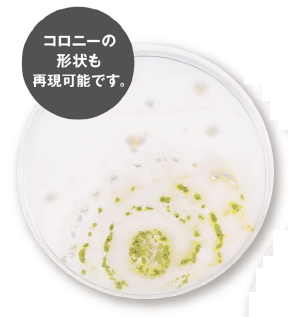
【食品サンプル模型 活用事例】微生物検査

測定・検査・センシングに関連する気になるカタログにチェックを入れると、まとめてダウンロードいただけます。
受入部品の品質信頼性とは?課題と対策・製品を解説

目的・課題で絞り込む
品質管理・検査工程
生産工程・プロセス
カテゴリで絞り込む
カメラ・顕微鏡 |
センサ |
計測機器 |
検査機器 |
試験機器 |
測定要素技術 |
測定製品・サービス |
その他測定・検査・センシング |

品質管理・検査工程における受入部品の品質信頼性とは?
各社の製品
絞り込み条件:
▼チェックした製品のカタログをダウンロード
一度にダウンロードできるカタログは20件までです。
密着力試験 付着力試験 クロスカット試験セット
ASMEの非破壊試験コンサルタント業務
受託検査サービス
建設材料試験
破袋強度試験機 シールテスター JC-01A-1507型
小型X線検査装置『Dylight』
ノードソンDAGE X線検査装置・X線CT装置
塗膜中の有害物質分析
携帯式臭気測定器・ニオイセンサーPOLFA
ハンドヘルド蛍光X線分析装置『VoXER』
建研式 接着剥離試験器『BA-800D』
現場帰りの残業を削減!アスベスト分析発注サービス|アルモバ
HFM 446 Lambda / 断熱材用熱伝導率測定装置
植込みボルトめねじ部検査サービス
【振動試験機】輸送包装試験機 BF-100UT
リサイクル材料試験
検査・試験関連カタログ
食品・商品検査『異物検査』
測定工具 硬度チェック HARDNESS TESTER
プラスチック材質判別装置『ぷらしる』
【食品サンプル模型 活用事例】微生物検査
アスベスト分析サービス
摩擦測定機 AN2(傾斜法・摩擦係数測定機)
業界最安値!最短当日結果報告!アスベスト分析ならベスター!!
真偽判定検査装置『SIGMASCOPE GOLD B』
食品サンプル模型 活用事例集
受託試験のご案内
データロガー おんどとり ■ TR-74Ui ■
リークテスター『LS3010』
建研式 接着剥離試験器『BA-450D』『BA-400D』

お探しの製品は見つかりませんでした。
1 / 1
品質管理・検査工程における受入部品の品質信頼性
品質管理・検査工程における受入部品の品質信頼性とは?
測定・検査・センシング業界において、品質管理・検査工程における受入部品の品質信頼性とは、外部��から調達した部品が、定められた品質基準を満たしており、かつ、その品質が安定して維持されることを指します。これは、最終製品の品質を保証し、製造プロセス全体の効率性と信頼性を高める上で極めて重要です。
課題
検査基準の曖昧さによる見逃し
受入部品の検査基準が不明確であったり、担当者によって解釈が異なったりすることで、本来不合格となるべき部品を見逃してしまうリスクがあります。
検査能力の限界と人的ミスの発生
目視検査や簡易的な測定器に依存する場合、微細な欠陥の発見が困難であったり、検査員の疲労や集中力の低下による人的ミスが発生しやすくなります。
トレーサビリティの欠如による原因究明の遅延
受入部品の検査履歴やサプライヤー情報が十分に記録・管理されていない場合、不良発生時の原因究明や対策立案に時間がかかり、再発防止が難しくなります。
サプライヤーごとの品質ばらつきへの対応不足
複数のサプライヤーから部品を調達している場合、サプライヤーごとの品質レベルのばらつきを十分に把握・管理できていないと、全体の品質安定に影響が出ます。
対策
検査基準の標準化と自動化
定量的な検査基準を明確に定義し、自動化された検査システムを導入することで、客観�的かつ高精度な検査を実現し、人的ミスを削減します。
高度なセンシング技術の活用
非破壊検査や画像認識、AIを活用した検査システムを導入し、人間の目では捉えきれない微細な欠陥や異常を検知します。
データ管理システムの導入と活用
受入部品の検査データ、サプライヤー情報、ロット情報などを一元管理し、リアルタイムでの品質状況把握と迅速な原因究明を可能��にします。
サプライヤー評価と連携強化
サプライヤーの品質管理体制を定期的に評価し、品質改善に向けた情報共有や共同での取り組みを進めることで、調達部品全体の品質レベルを向上させます。
対策に役立つ製品例
自動光学検査装置
高解像度カメラと画像処理技術により、部品表面の傷、異物混入、寸法不良などを自動で検出・判定し、検査の精度とスピードを向上させます。
非破壊検査システム
X線や超音波などの技術を用いて、部品内部の欠陥や構造的な問題を、破壊することなく検査し、隠れた不良を見つけ出します。
品質管理データ分析システム
受入部品の検査データ、生産ラインのデータなどを統合的に管理・分析し、品質傾向の可視化、異常検知、原因分析を支援します。
AI画像認識検査ソフトウェア
機械学習により、複雑な形状や多様な欠陥パターンを学習し、人手では判断が難しい不良も高精度に識別・分類します。
⭐今週��のピックアップ

読み込み中